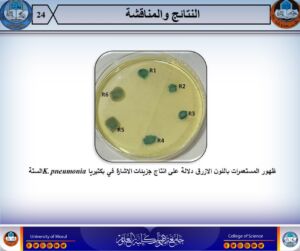

16 سبتمبر، 2025
رسالة ماجستير تناقش تشخيص البكتيريا المعزولة من حالات تجرثم الدم

ناقش قسم علوم الحياة في كلية العلوم – جامعة الموصل رسالة الماجستير الموسومة “تشخيص البكتيريا المعزولة من حالات تجرثم الدم وتثبيط التعبير الجيني لجينات مضادات الدفق للبكتيريا الأكثر عزلاً” يوم الثلاثاء الموافق 16 أيلول 2025، بحضور رئيس القسم الأستاذ الدكتور أمجد عبد الهادي وعدد من التدريسيين وطلبة الدراسات العليا.
قدمت الطالبة رسلية يونس محمود أحمد من فرع الأحياء المجهرية دراسة متكاملة ركّزت على الكشف عن قدرة سلالات Klebsiella pneumoniae على إنتاج جزيئات الإشارة ضمن ظاهرة Quorum Sensing (QS)، إضافة إلى تحري تأثير تراكيز مختلفة من فيتامين C في تثبيط إنتاج هذه الجزيئات عبر ظاهرة Quorum Quenching (QQ). كما اعتمدت الدراسة لأول مرة محليًا تقنية PFGE لتحديد العلاقة الوراثية بين السلالات ومصدر العدوى.
أبرز أهداف الدراسة شملت :
- عزل وتشخيص البكتيريا من حالات تجرثم الدم باستخدام فحص 16S rRNA.
- تحديد تحت النوع لسلالة pneumoniae الأكثر سيادة عبر اختباري Voges-Proskauer وفحص استهلاك المالونيت.
- تقييم تأثير تجرثم الدم على وظائف الكلى والقلب من خلال الفحوص المخبرية لمستوياتها في المصل.
- الكشف عن ظاهرة استشعار النصاب وقدرة السلالات على إنتاج جزيئات الإشارة طويلة السلسلة.
- التحري عن تأثير فيتامين C بتراكيز مختلفة على تثبيط إنتاج جزيئات الإشارة ضمن ظاهرة Quorum Quenching.
- تحديد النمط المصلي لمحفظة pneumoniae باستخدام تقنية PCR لمعرفة النمط السائد.
- إجراء التنميط الوراثي للسلالات المحلية باستخدام تقنية PFGE ورسم الشجرة الوراثية لتوضيح مدى التقارب الوراثي ومصدر العدوى.
ترأّس لجنة المناقشة الأستاذ الدكتور محمود زكي سليمان سلطان، وعضوية كل من الأستاذ المساعد الدكتور شاكر غازي جرجيس حسين والدكتورة ساهرة إدريس حميد أحمد، تحت إشراف وعضوية الأستاذ المساعد الدكتورة غادة عبد الرزاق محمد إبراهيم.
أهداف التنمية المستدامة المتماشية مع الرسالة :
- الهدف 3: الصحة الجيدة والرفاه : الرسالة تعزز فهم العدوى البكتيرية وتجرثم الدم، مما يساهم في تطوير طرق التشخيص والعلاج، وتحسين صحة المرضى ورفاههم.
- الهدف 9: الصناعة والابتكار والبنية التحتية : استخدام تقنيات حديثة مثل PFGE وPCR لأول مرة محليًا يعكس ابتكارًا علميًا في مجال الميكروبيولوجيا الطبية.
- الهدف 4: التعليم الجيد : إعداد الرسالة ومناقشتها يرفع مستوى التعليم والتدريب المتخصص لطلبة الدراسات العليا في علوم الحياة والأحياء المجهرية.
- الهدف 17: الشراكات من أجل الأهداف : الدراسة تدعم التعاون بين الباحثين والمختبرات، وتبادل المعرفة والخبرات العلمية محليًا ودوليًا.
وتعد هذه الدراسة خطوة علمية مهمة لتعزيز الفهم العلمي لسلوكيات سلالات K. pneumoniae في حالات تجرثم الدم، وفتح آفاق جديدة لتطوير استراتيجيات تثبيط نشاطها الجزيئي، بما يسهم في دعم جهود البحث العلمي والمكافحة الميكروبيولوجية محليًا.
تمنياتنا لطلبتنا الاعزاء دوام الموفقية والنجاح
شعبة الاعلام والاتصال الحكومي
الثلاثاء 16 أيلول 2025